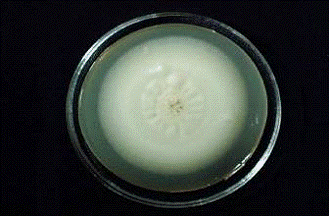
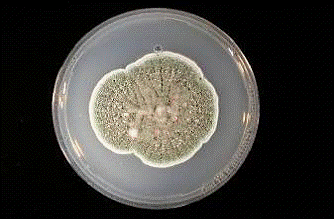

Морфолого-культуральні ознаки, екологія та практичне застосування в біотехнології грибів Penicillium funiculosum
КУРСОВА
РОБОТА
Морфолого-культуральні
ознаки, екологія та практичне застосування в біотехнології грибів Penicillium
funiculosum
РЕФЕРАТ
Дана курсова робота виконана згідно
отриманого завдання. Структура курсової роботи відповідає вимогам щодо порядку
оформлення курсових робіт, вказаних в «Методичних рекомендаціях до виконання
курсової роботи для студентів напряму підготовки 6.051401«Біотехнологія» денної
та заочної форм навчання».
Курсова робота присвячена вивченню
морфолого-культуральних ознак, екології та практичного застосування у
біотехнології грибів Penicillium
funiculosum.
Зокрема встановлено, що Penicillium
funiculosum
може бути використаний для синтезу вортманніну, який в свою чергу інгібує
фосфоінозитид-3-кінази, які беруть участь в канцерогенезі та рості пухлин.
Зміст даної курсової роботи
викладений на 19 сторінках. Курсова робота складається з вступу в якому
описується необхідність розвитку біотехнології, як науки, загальний опис грибів
роду Penicillium.
У розділі «Характеристика грибів Penicillium
funiculosum»
описується гриб данного виду, розкриваються його морфолого-культуральні ознаки,
біохімічні властивості.
У розділі «Практичне значення грибів
Penicillium
funiculosum»
розглядаються напрями в яких може бути використаний даний вид гриба, а саме для
синтезу вортманніну, що може бути використаний як протипухлинний засіб.
У розділі «Екологія грибів Penicillium
funiculosum»
розглядаються екологічні ніші Penicillium
funiculosum
у природних умовах, взаємовідносини з іншими мікро- та макроорганізмами.
Курсова робота викладена на 20
сторінках також містить 5 рисунків та таблицю, має список використаної
літератури з 11 найменувань, містить 2 додатка.
Ключові слова: Penicillium
funiculosum,
морфолого-культуральні ознаки, вортманнін, фосфоінозитид-3-кіназа .
Перелік
умовних позначень
PI3K Фосфоінозитид-3-кіназа (mechanistic
target of rapamycin) треонінова протеїнкіназа
МА Мальц-агар
CYA Czapek
Yeast Autolysate
agar (дріжджовий
автолізат агару Чапека)
GC вміст
гуанін-цитозин
PTEN ген
гомологу фосфатази та тензинуP Фосфатидилінозитол-3-фосфат(3,4,5)P3 Фосфатидилінозитол-3,4,5-трифосфат/IGF-1 Інсуліноподібний
фактор росту-1
ВСТУП
З огляду на достатньо швидкі темпи
розвитку біотехнології, можна зробити висновок, що потреби людства ростуть.
Тому в роботі найбільше значення надається практичному значенню та перспективам
використання грибів виду Penicillium
funiculosum.
Століттями гриби служили для людини, з плином часу люди навчилися
використовувати майже всі переваги такого «співжиття», і згодом почали шукати
нові перспективи їх використання. Таким чином був відкритий та виділений перший
антибіотик - пеніцилін. Саме з того моменту мікробіологія стала однією з
найперспективніших галузей в науці. З часом на допомогу їй прийшли генна інженерія
та біотехнологія. Та як саме тема роботи безпосередньо стосується
біотехнології?
Біотехнологія - це комплекс
фундаментальних і прикладних наук, технічних засобів, спрямованих на одержання
і використання клітин мікроорганізмів, тварин і рослин, а також продуктів їх
життєдіяльності: ферментів, амінокислот, вітамінів, антибіотиків та ін.
Біотехнологія, яка включає промислову мікробіологію, базується на використанні
знань і методів біохімії, мікробіології, генетики і хімічної технології, що дає
змогу діставати користь у технологічних процесах із властивостей
мікроорганізмів та клітинних культур[1].
Що стосується сучасніших
біотехнологічних процесів, то вони базуються на методах рекомбінантних ДНК, а
також на використанні іммобілізованих ферментів, клітин і клітинних органел.
Біотехнологічні процеси з використанням мікроорганізмів і ферментів уже на
сучасному технічному рівні широко застосовуються у харчовій промисловості.
Промислове вирощування мікроорганізмів, рослинних і тваринних клітин
використовують для одержання багатьох цінних сполук - ферментів, гормонів,
амінокислот, вітамінів, антибіотиків, метанолу, органічних кислот (оцтової,
лимонної, молочної) і т. д. За допомогою мікроорганізмів проводять
біотрансформацію одних органічних сполук в інші (наприклад, сорбіта у
фруктозу)[2].
Одним із таких напрямків є
використання грибів аскомікотів роду Penicillium.
Даний рід грибів поширений повсюдно окрім полярних регіонів та пустель.
Аскомікотові гриби або сумчасті гриби (Ascomycota) - відділ грибів, що об'єднує
організми з септованим міцелієм і специфічними органами статевого спороношення
- сумками (асками), що частіше всього містять по 8 аскоспор. Аскомікотові гриби
здатні до безстатевого спороношення (конідієношення), причому у багатьох
випадках і статевий процес, і статеве спороношення втрачаються (такі види
грибів раніше відносили до групи недосконалих грибів, Deuteromycota)[3].
В основному конідієносці у грибів
роду Penicillium
на верхівці китицевидно розгалужені, конідії утворюються в ланцюжках. Іноді
конідієносці з’єднані у пучки (коремії). Конідії овальні іноді округлі, гладкі.
Систематика цього роду грибів базується на будові китиці, формі та розмірах
конідій, морфології колоній (колонії зональні, азональні, складчасті, повстисті
тощо), на забарвленні та, часом, фізіологічних властивостях, здатності
розріджувати желатину тощо. Гриби роду Penicillium є продуцентами ефективних
антибіотичних препаратів, зокрема пеніциліну та мікроциду. Антибіотики,
одержані з цих грибів, використовуються в медицині, сільському господарстві та
промисловості. У природних умовах види роду Penicillium відомі як сапротрофи в
грунті, на харчових продуктах, зерні хлібних злаків, сіні, соломі та інших
грубих кормах. Гриби цього роду використовують і для синтезу ферментів,
органічних кислот, білків, вітамінів та ін. Спектр їх використання постійно
збільшується, з розвитком генної інженерії цей рід став «синтетичною
лабораторією», адже багато речовин які синтезують інші мікроорганізми в десятки
разів краще синтезуються грибами-пеніцилами. Також сири Рокфор та Камамбер
неможливо було б виготовити без участі Penicillium roqueforti та Penicillium
camemberti. Однак гриби можуть нести не тільки користь, а й шкоду, багато видів
спричинюють хвороби рослин, тварин, а вид Penicillium marneffei викликає
пеніцильоз - захворювання людини. Однак темою моєї роботи було вивчення гриба
іншого виду - Penicillium
funiculosum.
Вперше цей вид був описаний Чарльзом
Томом в 1910 році, гриб був відкритий разом з багатьма іншими видами, висіяний
з пилу старої шкіряної рукавиці, Тому він здався геть непотрібним. Як
з’ясувалося цей вид ще й викликає захворювання рослин, тому його швидко
витіснили гриби з більш кориснішим застосуванням. Однак пізніше з’ясувалося що
гриби цього виду синтезують дуже корисну речовину, вортманнін.
Вортманнін (англ. wortmannin) -
хімічна сполука біологічного походження фураностероїдний метаболіт грибів Penicillium
funiculosum
та Talaromyces (Penicillium) wortmannii. Антигрибковий препарат, специфічний
інгібітор клітинних фосфоінозитид-3-кіназ. Вортманнін являє собою специфічний
ковалентний інгібітор фосфоінозитид-3-кіназ і широко застосовується в клітинній
біології. Інгібує всі три класи фосфоінозитид-3-кіназ. При більш високих
концентраціях інгібує також деякі інші PI3K-
подібні ферменти, такі як фосфоінозитид-4-кінази та mTOR. Вортманнін також
інгібує ферменти із сімейства поло-подібних кіназ. В клітинній культурі
вортманнін дуже нестійкий, час його напіврозкладу становить 10 хвилин.
Використовується в клітинній біології як інгібітор рецепторно-опосередкованого
ендоцитозу. Структурна та просторова формула див. (Додаток 1).
РОЗДІЛ 1
ХАРАКТЕРИСТИКА ГРИБІВ Penicillium
funiculosum
.1
Характеристика виду Penicillium funiculosum
Гриб Penicillium
funiculosum(Рис.1.1.)
широко розповсюджений в помірних та тропічних широтах. Цей вид був виділений з
різних субстратів, таких як папір, шкіра, вода(солончаки,болота), відкладення
гирл річок, дюн, атмосферний пил, грунтовий пил, продукти харчування(фрукти,
фруктові сиропи, бобові паростки, крупи, горіхи). Слугує їжею для деяких видів
кліщів, таких як: Caloglyphus redikorzev, Acarus gracilis, Glycyphagus
destructor. Виділяє токсини гіберелін та патулін, а також ферменти
карбоксипептидаза та целюлаза. Іноді паразитує на рослинах, зокрема на коренях
проростків кукурудзи, на грибах аспергілах, поселяється також на личинках
деяких видів комарів. Його спори, що знаходяться в повітрі, можуть бути
причиною алергічних явищ (астми, сінної лихоманки). Цей гриб також нерідко
викликає отомікози. Він входить до групи грунтових грибів-токсиноутворювачів і,
зокрема, пригнічує розвиток в грунті азотфіксуючих бактерії Azotobacter
chroococcum. Його також часто можна побачити на бавовняних речах, за умови
достатнього зволоження, також на шкірі та пергаменті. На папері та бавовні він
має білий колір на шкірі та пергаменті, спочатку білий, а з віком сіріє. Згідно
нової систематики даний вид розташований так, як показано в таблиці 1.1
гриб penicillium funiculosum вортманнін

Рис.1.1 Вигляд Penicillium
funiculosum
в світловому мікроскопі
Таблиця 1.1 Філогенетична
класифікація Penicillium
funiculosum
|
№ п/п
|
|
|
|
1
|
Царство
|
Гриби
|
|
2
|
Відділ
|
Аскоміцети
|
|
3
|
Клас
|
Eurotiomycetes
|
|
4
|
Порядок
|
Eurotiales
|
|
5
|
Родина
|
Trichocomaceae
|
|
6
|
Рід
|
Penicillium
|
|
7
|
Секція
|
Biverticillata
|
|
8
|
Вид
|
funiculosum
|
.2
Культуральні ознаки Penicillium funiculosum
Загальні морфолого-культуральні
ознаки роблять його досить схожим на інші види роду
Penicillium.
Має округлі колонії 3-5 мм в діаметрі, в залежності від щільності посіву, можуть
досягати 11 мм в діаметрі. Поверхня колоній слабо шорстка, пухка, консистенція
м’яка. Повітряний міцелій має колір від білосніжно-білого до сірувато-зеленого.
Тривалість розвитку гриба становить 36-40 днів. Репродуктивними органами є
конідієносці з конідіями(спори), можливе також вегетативне
розмноження(частинами міцелію). Конідії еліптичні в деяких штамів сферичні,
гладкі.
При рості на МА(25°С) діаметр
колоній досягає 36 мм на 7 добу росту. Колонії рівні, щільні з випуклим
центром. Міцелій світлий, пухкий. Зворотна сторона палево-червонувато-оранжева,
іноді жовтувата. (див. Додаток 2)
Колонії на CYA
на 7 добу мають 27-30 мм в діаметрі, складчасті, з рівним краєм, поверхня
шорстка. Міцелій світлий, жовтуватий. Зворотня сторона палево-оранжева, іноді
блідо-рожеве. Іноді колонії бархатисті.(Додаток 2)
При культивуванні на агарі
Чапека(37°С) колонії мають 18 мм в діаметрі, складчасті, середньої щільності,
зворотна сторона коливається від блідо-рожевого кольору до буро-червоного чи
іноді коричнево-червоного. Також при рості на цьому середовищі, старі культури
мають стійкий неприємний запах.(Додаток 2) Гриб не росте на середовищі з
гліцерином і на агарі Чапека при 5°С.
1.3
Морфологічні ознаки Penicillium funiculosum
Загальний вигляд гриба Penicillium
funiculosum
такий: конідієносці гладкі 26-60 мкм довжиною в групах від 5 до 8 Конідіогенез
слабкий, сіро-зеленого відтінку. Міцелій дуже галузистий, септований.
Конідіогенез: китиці
бівертицеллятні, метули прижаті, гладкі(8-10×2,5-3,0).
Фіаліди ацерозні(8-9×2,5-3,0),
з короткою шийкою. Конідії еліптичні, дрібні(2,2×1,5-2,0),
гладкі.
При культивуванні в глибинних умовах
з використанням розчинних субстратів(глюкоза, фруктоза, лактоза) утворюється
міцелій зі слабкою пелетизацією. питома початкова швидкість росту міцелію
складає 0,35 ч-1, в кінці культивування 0,1 ч-1.
Penicillium
funiculosum
є факультативним тонофілом. Його зростання відбувається в межах таких
температур 8-42°C
з
оптимумом при 25-28°C.
Цей вид може витримувати нагрівання до 70°C
протягом 30 хвилин. Також цей вид грибів являється факультативним ацидофілом
(невибагливим до кислого середовища), нормально розвивається на грунтах при рН
близько 2. Аналіз ДНК показує що штам має 49,5-50 GC
вмісту[5].
1.3
Біохімічні властивості Penicillium funiculosum
Так як всі гриби являються
гетеротрофами, P.
funiculosum
не є виключенням, для своєї життєдіяльності в якості джерела вуглецю він
використовує[6]:
· глюкозу, сахарозу,
мальтозу, крохмаль або галактозу.
· гліцин, аспарагін,
нітрат натрію чи калій нітрат.
Крім цього він може псувати такі
сполуки:
· саліцин з виходом
бета-глюкозидази
· декстран з виходом
декстранази(даний фермент використовується для запобігання утворення зубного
нальоту)
· целобіозу, ксилан,
1,2-бета-глюкан
· манозу, глюкозу,
крохмаль з виходом екзо-1,3-альфа-глюканази та бета-манозидази
· вуглеводні
· поліуретани(термопластичні
смоли)
Також гриб може синтезувати багато
органічних, корисних для людини сполук:
· оцтова-3-індол
кислота
· карбоксипептидазна
кислота
· антибіотики з
невисокими бактерицидними та фунгіцидними властивостями
· целюлази(1-бета-глюкозидаза,
2,1,4-бетаглюкан целлобіогідролаза, 3,1,4-бетаглюкан-глюканогідролаза)
· холестерин та інші
стерини
· гібереліни
· парулін(мікотоксин)
· вортманнін
РОЗДІЛ 2 ПРАКТИЧНЕ ЗНАЧЕННЯ Penicillium
funiculosum
В наш час широко застосовуються
речовини, синтезовані бактеріями, грибами чи одноклітинними тваринами. До таких
мікроорганізмів належить й P.
funiculosum,
який синтезує цілий спектр органічних речовин серед яких є специфічна, так як
її можуть синтезувати лише деякі організми, - це вортманнін.
Вортманнін (англ. wortmannin) -
хімічна сполука біологічного походження фураностероїдний метаболіт грибів Penicillium
funiculosum
та Talaromyces (Penicillium) wortmannii. Антигрибковий препарат, специфічний
інгібітор клітинних фосфоінозитид-3-кіназ. Вортманнін являє собою специфічний
ковалентний інгібітор фосфоінозитид-3-кіназ і широко застосовується в клітинній
біології. Інгібує всі три класи фосфоінозитид-3-кіназ. При більш високих концентраціях
інгібує також деякі інші PI3K-
подібні ферменти, такі як фосфоінозитид-4-кінази та mTOR. Вортманнін також
інгібує ферменти із сімейства поло-подібних кіназ. В клітинній культурі
вортманнін дуже нестійкий, час його напіврозкладу становить 10 хвилин.
Використовується в клітинній біології як інгібітор рецепторно-опосередкованого
ендоцитозу.
Виявлена у PI3K онкогенна активність
свідчить про важливу роль цього ферменту в процесі канцерогенезу і росту
пухлин. Дійсно, в окремих роботах відзначалися зміни рівня фосфоінозитидів при
розвитку злоякісних новоутворень[9].
У дослідженнях при аналізі експресії PI3K в пухлинах молочної залози в 79% була
виявлена суттєва
активація PI3K порівняно з прилеглою нормальною тканиною. Порівняно недавно
встановлено, що дія деяких генів - супресорів пухлинного росту, - реалізується
через придушення активності PI3K. Зокрема, такими властивостями володіє продукт
гена-супресора PTEN. Специфічні інгібітори PI3K (вортманін, LY 294002)
викликають суттєве гальмування росту клітин у культурі і перешкоджають
пухлинної трансформації in vitro. PI3K не тільки володіє самостійною онкогенною
активністю, а й потенціює дію інших онкогенів, активуючи і посилюючи
трансформуючу активність багатьох з відомих онкобілків[10]. Інгібування РІ3К
забезпечує сильну протипухлинну активність, а також сприяє підвищенню
чутливості пухлини до широкого спектру дії лікарських засобів.
Поява нових знань у галузі
молекулярної біології дозволила виявити участь ряду шляхів передачі сигналу в
патогенезі розвитку і прогресування нирково-клітинного раку (ПКР), завдяки чому
виникла ідея створення так званих таргетних препаратів, специфічно інгібуючих
ці шляхи, серед яких, вортманнін, який інгібує не тільки РІ3К але й mTOR.
Також вортманнін може
застосовуватись для попередження завчасної аутофагії клітин, викликаної
метаболічною стресовою ситуацією, чи іншими факторами, що збільшує вірогідність
виживання клітин, яка досить сильно необхідна при пересадці органів чи шкіри.
Основним негативним регулятором
макро-аутофагії є кіназа mTOR, яка, як правило, запускає базове утворення
аутофагосом, але її інгібування (наприклад, за допомогою рапаміціна[антибіотик,
імунодепресант, застосовується для боротьби з відторгненням пересаджених
органів і тканин, особливо нирок] при відсутності поживних речовин) запускає
макро-аутофагію. Придушення mTOR активності сприяє ферментативної активації
мультипротеїнового комплексу, який формується з PI3K, та інших білків. Цей
комплекс стимулює інші білки які стимулюють вироблення PtdInsP3,
(молекулярний сигнал для збірки аутофагових комплексів), що формує подовження
та закриття везикул. Процес макро-аутофагії можна інгібувати по шляху
insulin/IGF-1, де PI3K продукують PtdIns(3,4,5)P3, які стимулюють функцію mTOR.
Однак шлях insulin/IGF-1 сигналізації має патогенну роль в розвитку раку, тобто
вводить фактори ризику для людини.
Дослідження показали, що при
підвищеному рівні insulin/IGF-1 посилюється ріст ракових клітин[11]. Тобто
інгібування mTOR
активності за допомогою рапаміцину не є ефективним, адже збільшується
вірогідність росту ракових клітин не тільки через підвищення рівня
insulin/IGF-1, а й через активацію РІ3К-комплексу, але вортманнін, не має
такого ефекту, він блокує як mTOR
так і РІ3К, що унеможливлює проходження інгібуваня по шляху insulin/IGF-1, та в
свою чергу запобігає розвитку ракових клітин.
Це означає що даний вид гриба може
активно застосовуватись для боротьби з онкозахворюваннями, або призупиняти їх
на ранніх стадіях розвитку. А також збільшувати вірогідність приживання
пересаджених органів, без побічного впливу.
Також P.
funiculosum
гальмує проростання помідорів, редису та баклажанів. Деякі його штами можуть
абсорбувати уран з мінералів[4].
Фільтрати культури та екстракти міцелію P.
funiculosum
володіють терапевтичними властивостями проти свинячого грипу, вірусу лісу
Семілкі та мишиного енцефаломієліту.
Крім цього, штам Penicillium
funiculosum ВКМ F 3668D має здатність продукувати комплекс високоактивних
карбогідраз, що включає целюлази, глюканази, ксиланази, пектинази і маннанази,
що створює можливість отримання набагато більш активного і повного комплексу
ферментів, а також при необхідності окремих індивідуальних ферментів комплексу.
Препарати, отримані на основі пропонованого штаму, дозволяють істотно збільшити
ефективність і розширити спектр використання ферментних препаратів у різних
областях біотехнології і, особливо, в якості кормових добавок[8].
РОЗДІЛ 3
ЕКОЛОГІЯ Penicillium funiculosum
В наш час, найбільше зростає
цікавість до вивчення різноманітності міксоміцетів в різних екологічних нішах.
Про що свідчать роботи, що з’явилися не так давно. В них описується мікрофлора,
характерна для різноманітних функціональних та саморегулюючих екосистем.
Дослідження, виконані в одному з
книгосховищ Російської національної бібліотеки показали, що досить широкого
поширення мають види родів Penicillium
та Aspergillus.
В деяких випадках, вони навіть в ходять в число домінуючих видів. Не являючись
специфічними для якого-небудь одного фонду, вони, в той же час, були
характерними для певного типу книгосховищ.
Цікавість представляють данні,
отримані в неблагополучному по режиму зберігання книг фонді. В цілому, видовий
склад тут був досить невеликим. При цьому переважна більшість з них відомі як
целюлозоруйнуючі гриби. В результаті порівнюючого аналізу пробах з повітря були
виділені групи видів, що різняться за ступенем специфічності. Домінуючими були Penicillium
funiculosum,
Penicillium
fellutanum, Aspergillus terreus, Aspergillus
niger. Також були відмічені й інші види,
які досить рідкісні як для такого місця. За відсотковим співвідношенням
найбільшу частку мікрофлори займав Penicillium
funiculosum
- 40%. Що свідчить про досить сильне його поширення в таких місцях.
Крім цього та території заводу
поблизу міста Ухти, були проведені дослідження підзолистих грунтів. Проведені
дослідження показали, що у всіх варіантах грунтових зразків, крім техногенно
порушених, мікробіота відповідає зрілій стабільно функціонуючій екосистемі.
Переважаючими були види родів Penicillium
та Trichoderma.
Також дослідження проводилися і на грунтах, забруднених техногенно, а саме за
рахунок нафтопереробного заводу. Особливу цікавість викликає поява таких видів
грибів що не типові для грунтів цих широт: Aspergillus
fumigatus,
Aureobasidium
pullulans
та Penicillium
funiculosum,
що мають високу наявність на забруднених грунтах поблизу заводу і повністю
зникають уже за 500 метрів від нього.
Аналізуючи результати, можна зробити
висновок, що Penicillium funiculosum,
Aureobasidium
pullulans, P.
purpurogenum,
Aspergillus
fumigatus, Trichoderma
aureviride, а також Penicillium
commune, Trichoderma
sympodianum
і Mortierella
isabellina є
індикаторами на дане забруднення, при чому про перші 5 видів можна говорити, як
про найстійкіші, а про останні 3, як про найчутливіші мікроміцети до даного
виду забруднень.
Тож гриб Penicillium
funiculosum,
поширений в досить очікуваних місцях, таких як: бібліотеки, книгосховища,
паперові фабрики і т. д. Так і в зовсім неочікуваних, таких як, нафтопереробний
завод на півночі Росії, хоча ареал його поширення закінчується на північних
широтах помірного поясу, а звичним місцем поширення є субтропіки.
Можна також додати що Penicillium
funiculosum
служить кормом для таких видів кліщів: Caloglyphus redikorzev, Acarus gracilis,
Glycyphagus destructor. Деякі з них викликають алергію та астму у людей, а
також шкірні захворювання. Знищення гриба призведе до голодування кліщів, які в
свою чергу також зникнуть через брак їжі.
вИСНОВКИ
1. Гриб Penicillium
funiculosum
широко розповсюджений в помірних та тропічних широтах.
2. Penicillium
funiculosum
є факультативним тонофілом. Його зростання відбувається в межах таких
температур 8-42°C
з оптимумом при 25-28°C.
Цей вид може витримувати нагрівання до 70°C
протягом 30 хвилин. Також цей вид грибів являється факультативним ацидофілом.
. Даний вид
гриба виробляє речовину фураностероїдного походження, вортманнін (специфічний
інгібітор клітинних фосфоінозитид-3-кіназ),
яка може активно застосовуватись для боротьби з онкозахворюваннями, або
призупиняти їх на ранніх стадіях розвитку. А також збільшувати вірогідність
приживання пересаджених органів, без побічного впливу, завдяки речовині
вортманінн, яку він синтезує.
. Penicillium funiculosum є
індикатором на забруднення нафтопродуктами, що доводять проведені експерименти
поблизу міста Ухти.
. Штам Penicillium
funiculosum ВКМ F 3668D має здатність продукувати комплекс високоактивних
карбогідраз, що включає целюлази, глюканази, ксиланази, пектинази і маннанази,
що створює можливість отримання набагато більш активного і повного комплексу
ферментів.
СПИСОК ЛІТЕРАТУРИ
1. Быховский
В.Я. Микробиология. - М.: Мир, 1998. - 320 с.
2. Маруненко
І.М., Біотехнологія: перспективи розвитку//Відкриття і гіпотези, №7, 1997. -
32-34 с.
3. Пирог
Т.П. Загальна мікробіологія: Підручник. - К.: НУХТ, 2004. - 471 с.
4. Geomicrobiology,//
Journal,
28:471-482, 2011. UK
5. Botton
B., Breton A., Fèvre
M., Guy Ph., Larpent J.P., Veau P. (1985) Moisissures utiles et nuisibles.
Importance industrielle. Ed. Masson, p 174, 212, 214, 218, 293, 308
6. Abdel-Hafez
S.I., Shoreit A.A., Abdel-Hafez A.I., Maghraby O.M. (1986) Mycoflora and
mycotoxin-producing fungi of air-dust particles from Egypt Mycopathologia 93
(1), 25-32
7. Montegut
D., Indictor N., Koestler R.J. (1997) Cellulolytic textiles : a review.
International biodeterioration and biodegradation 28 (1-4), 209-226
8. Пат.
№2195490 С2 RU. Штамм мицелиального гриба Penicillium
funiculosum - продуцент
комплекса карбогидраз, содержащего целлюлазы, бета-глюканазы, ксиланазы,
пектиназы и манназы. - Опубл. 27.12.2002
9. Huang
C., Schmid P., Ma W., Schmid H. and Dong Z. 1997,//
J. Biol. Chem., 272, 4187-4194.
. Fukui
Y. and Hanafusa H. 1989, //Mol.
Cell. Biol. 9, 1651-1658.
. Bordoni
A., Hrelia S., Biagi P. and Berra B. 1992, Int. //J.
Cancer, 50, 402-404
Додаток 1


Просторова та структурна формули
вортманніну
Додаток 2
Колонія Penicillium
funiculosum
на Мальц-агарі

Колонія Penicillium
funiculosum
на CYA
Колонія Penicillium
funiculosum
на агарі Чапека